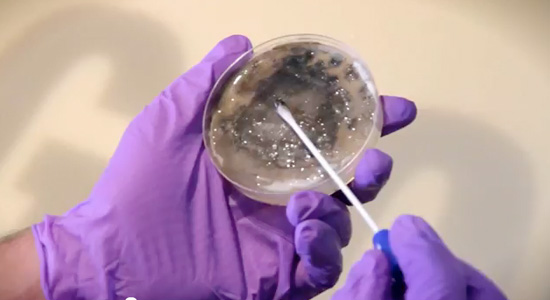
"Заразная" реклама (фото 1)

"Заразная" реклама
Рекламный щит из бактерий
Реклама фильма Стивена Содерберга "Зараза" (Contagion) оказалась вирусной, а точнее, бактериальной, в прямом смысле этого слова. Дело в том, что креативным директорам рекламного агентства Lowe Roche пришла в голову идея сделать единственную в своем роде рекламу из бактерий. Чтобы осуществить эту идею, они обратились к CURB Media — агентство, занимающееся изготовлением рекламы из живых материалов, например, из травы или из бактерий, светящихся в темноте. В результате группа ученых нарисовала "заразой" название фильма Contagion на двух рекламных щитах, которые разместили в витринах заброшенного здания в Торонто. По сюжету фильма "Зараза" всю планету охватывает вирус, передающийся по воздуху, который убивает человека в течение нескольких дней. Идеей рекламщиков было визуализировать "Заразу".
Команда из 25 микробиологов и иммунологов занималась созданием рекламных щитов, использовав для этого более 35 видов бактерий, включая пенициллин, плесень и пигментированную бактерию. У ученых было много проблем: надо было создать атмосферу, в которой бактерии бы медленно выросли в название фильма. Также надо было убедиться, что результат химической реакции будет яркого цвета и что бактерии будут расти вертикально.

Создатели рекламы уверяют, что все бактерии, использованные в создании рекламных щитов, безвредны и большинство из них окружают нас каждый день. Прохожие могли наблюдать за ростом "заразы" в Торонто в течение 5 дней, затем щиты сняли. Авторы говорят, что, если бы рекламу не трогали, бактерии в результате разрослись бы в нечто хаотичное.

"Зараза" произвела фурор в интернете: на данный момент видео на YouTube, показывающее весь процесс, а также то, какими стали со временем щиты, набрало более 30 000 просмотров.
Фильм "Зараза", в котором снялись Мэтт Дэймон, Гвинет Пэлтроу, Марийон Котийяр, Кейт Уинслет и Джуд Лоу, выйдет в российский прокат 13 октября. 
Текст: Карина Старобина